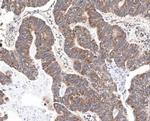
Survivin Antibody in Immunohistochemistry (Paraffin) (IHC (P))

Search
Invitrogen
Survivin Polyclonal Antibody
{{$productOrderCtrl.translations['antibody.pdp.commerceCard.promotion.promotions']}}
{{$productOrderCtrl.translations['antibody.pdp.commerceCard.promotion.viewpromo']}}
{{$productOrderCtrl.translations['antibody.pdp.commerceCard.promotion.promocode']}}: {{promo.promoCode}} {{promo.promoTitle}} {{promo.promoDescription}}. {{$productOrderCtrl.translations['antibody.pdp.commerceCard.promotion.learnmore']}}
图: 1 / 11
Survivin Antibody (PA5-27087) in ICC/IF

Please note: We are reviewing Western blot images included in the antibody testing data in our catalog, including those provided by third parties. Unless expressly labeled or annotated as “raw-unedited”, Western blot images included in the antibody testing data in our catalog may have been edited, optimized or otherwise adjusted for presentation.
产品信息
PA5-27087
种属反应
宿主/亚型
分类
类型
抗原
偶联物
形式
浓度
规格
纯化类型
保存液
内含物
保存条件
运输条件
RRID
产品详细信息
Recommended positive controls: 293T, HeLa.
Store product as a concentrated solution. Centrifuge briefly prior to opening the vial.
靶标信息
Survivin (IAP4) is the smallest member of the Inhibitors of Apoptosis Protein (IAP) gene family. The IAPs are involved in multiple cell functions such as cell signaling, cell division, metabolism, and exhibits differential expression in nearly all human cancers, but not in most normal tissues. IAP family members usually contain multiple baculovirus IAP repeat (BIR) domains, but the Survivin gene encodes proteins with only a single BIR domain. The encoded proteins also lack a C-terminus RING finger domain. Gene expression is high during fetal development and in most tumors yet low in adult tissues. Antisense transcripts are involved in the regulation of survivin's gene expression. Survivin is expressed in the G2/M phase of the cell cycle in a cycle-regulated manner. At the beginning of mitosis, survivin associates with microtubules of the mitotic spindle in a specific and saturable reaction that is regulated by microtubule dynamics. Disruption of survivin-microtubule interactions results in loss of survivin's anti-apoptosis function and increased caspase-3 activity, a mechanism involved in cell death, during mitosis. Survivin may counteract a default induction of apoptosis in G2/M phase. Survivin is also abundantly expressed in brain tissues (astrocytes and some neurons) of adult rats following traumatic brain injury. Survivin has been found co-expressed with NeuN (mature neuronal marker) and PCNA (a cell cycle protein). Survivin might affect regulation of neural cell proliferative responses after brain injury. At least four transcript variants encoding distinct isoforms have been found for this gene, but the full-length natures of only three of them have been determined. The overexpression of survivin in cancer may overcome this apoptotic checkpoint and favor aberrant progression of transformed cells through mitosis.
⚠WARNING: This product can expose you to chemicals including mercury, which is known to the State of California to cause birth defects or other reproductive harm. For more information go to www.P65Warnings.ca.gov.
仅用于科研。不用于诊断过程。未经明确授权不得转售。
篇参考文献 (0)
生物信息学
蛋白别名: anti-apoptosis protein; IAP; Apoptosis inhibitor 4; Apoptosis inhibitor survivin; baculoviral IAP repeat-containing 5; Baculoviral IAP repeat-containing protein 5; BIRC 5; BIRC5; EPR 1; IAP; survivin; SVV; TIAP; unnamed protein product
基因别名: AAC-11; API4; BIRC5; EPR-1; IAP4; survivin40; TIAP
UniProt ID: (Mouse) O70201
Entrez Gene ID: (Human) 332, (Mouse) 11799




